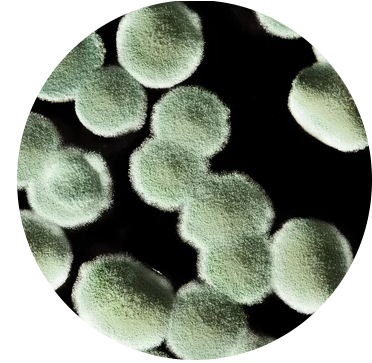

FAQs
See below for information about our services, if you may have any other questions please don’t hesitate to contact us.
WATER
-
Depending on the material affected, it may take up to 72 hours for one room to dry. Once water has completely dried, reconstruction can approximately 1-2 weeks.
-
The Standard Home Insurance Covers:
Sudden indoor source of water damage; such as burst pipes and sudden leaks
Few external source of water damage; such as rain entering from hole in roof or broken window (if had been listed in your policy)
Standard home insurance won’t cover:
Flooding
Water Back-Ups
Preventable Damages
MOLD
-
Mold can spread and deteriorate your property in a short time span. It is vital you contact a specialist to reduce the risk of further damages.
-
Mold reproduces through tiny spores invisible to the naked eye and floats throughout outdoor and indoor air, landing on wet surfaces, which help them grow. Mold’s various entryways can be through things such as windows, doors, HVAC systems, clothing and even pets. So once the spores find their way onto moisture, it can take less than 72 hours for the mold to spread throughout your property.
-
Absolutely! Mold only grows when there is moisture. Controlling humidity levels and addressing all moisture issues within your property can prevent indoor mold growth.
FIRE
-
Depending on the types of damage that has occurred after the fire, such as mold or water damage, the process can take up to a few day to several months to fully restore your property.
-
Based on the extent of damage and the floor plan, it may or may not be safe to remain on site.
-
Board-Ups & Tarp Servicing :
To protect against further damages and secure your property, SavePro technicians may board up walls, windows, or place tarps on the roof.
Water Mitigation:
If the fire has been put out by water or has caused water damage, a water mitigation process will be needed to prevent mold or other issues.
Smoke & Soot Removal:
It is important to remove all smoke and soot thoroughly as soon as possible. Leftover debris and particles can be hazardous to your health.
BIOHAZARD
-
Biosafety is the application of safety precautions taken to reduce risk of exposure to infectious microbes and limit the contamination of environments and communities. Each biosafety level has its own specific containment controls that requires certain practices, safety equipment.
-
Please do not attempt to clean hazardous materials yourself if you do not have professional training. Doing so may cause the risk of exposing yourself and others to harmful containments.